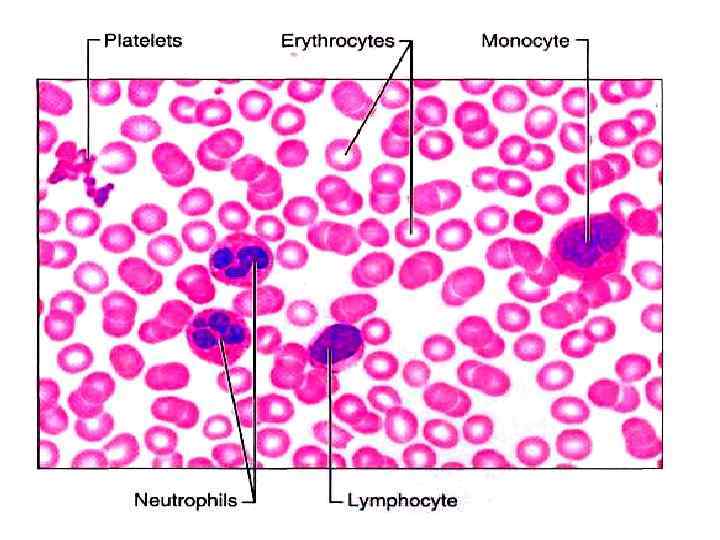

1-3. Лц-12-13 ФЭК 1209031015-3.ppt
- Количество слайдов: 194
 Лекция № 1 (часть третья) Тема: Форменные элементы крови. Группы крови. Медицинский факультет Специальности: лечебное дело, педиатрия 2012 / 2013 учебный год 3, 10 сентября 2012 г.
Лекция № 1 (часть третья) Тема: Форменные элементы крови. Группы крови. Медицинский факультет Специальности: лечебное дело, педиатрия 2012 / 2013 учебный год 3, 10 сентября 2012 г.
 Литература основная Физиология человека Под редакцией В. М. Покровского, Г. Ф. Коротько Медицина, 2003 (2007) г. С. 237 -260, 272 -273
Литература основная Физиология человека Под редакцией В. М. Покровского, Г. Ф. Коротько Медицина, 2003 (2007) г. С. 237 -260, 272 -273
 Литература основная Физиология человека В двух томах. Том I. Под редакцией В. М. Покровского, Г. Ф. Коротько • Медицина, 1997 (1998, 2000, 2001) г. С. 285 -313
Литература основная Физиология человека В двух томах. Том I. Под редакцией В. М. Покровского, Г. Ф. Коротько • Медицина, 1997 (1998, 2000, 2001) г. С. 285 -313
 Вопрос 1 Понятие «форменные элементы крови» С. 237
Вопрос 1 Понятие «форменные элементы крови» С. 237
 Значение слова "Форменные элементы крови" в Большой Советской Энциклопедии • Форменные элементы крови плотная фракция крови, состоящая из эритроцитов, лейкоцитов и тромбоцитов.
Значение слова "Форменные элементы крови" в Большой Советской Энциклопедии • Форменные элементы крови плотная фракция крови, состоящая из эритроцитов, лейкоцитов и тромбоцитов.
 Форменные элементы крови • Эритроциты • Тромбоциты • Лейкоциты
Форменные элементы крови • Эритроциты • Тромбоциты • Лейкоциты
 Форменные элементы крови • Эритроциты – постклеточные структуры • Тромбоциты – постклеточные структуры • Лейкоциты – клеточные структуры • Поэтому термин «форменные элементы крови» более строгий, чем «клетки крови» .
Форменные элементы крови • Эритроциты – постклеточные структуры • Тромбоциты – постклеточные структуры • Лейкоциты – клеточные структуры • Поэтому термин «форменные элементы крови» более строгий, чем «клетки крови» .
 Форменные элементы крови • Эритроциты • Тромбоциты • Лейкоциты Чего больше?
Форменные элементы крови • Эритроциты • Тромбоциты • Лейкоциты Чего больше?
 Количество • эритроцитов: мужчины 4, 0— 5, 1 ∙ 1012/л, женщины 3, 7— 4, 7 ∙ 1012/л • тромбоцитов: 180— 320 ∙ 109/л • лейкоцитов: 4, 0— 8, 8 ∙ 109/л
Количество • эритроцитов: мужчины 4, 0— 5, 1 ∙ 1012/л, женщины 3, 7— 4, 7 ∙ 1012/л • тромбоцитов: 180— 320 ∙ 109/л • лейкоцитов: 4, 0— 8, 8 ∙ 109/л
 Количество по старому • эритроцитов: 4, 0— 5, 1 ∙ млн. / мкл • тромбоцитов: 180— 320 ∙ тыс. / мкл • лейкоцитов: 4, 0— 8, 8 ∙ тыс. / мкл
Количество по старому • эритроцитов: 4, 0— 5, 1 ∙ млн. / мкл • тромбоцитов: 180— 320 ∙ тыс. / мкл • лейкоцитов: 4, 0— 8, 8 ∙ тыс. / мкл
 Гематокрит отношение объёма форменных элементов к объёму крови.
Гематокрит отношение объёма форменных элементов к объёму крови.
 Вопрос 2 Эритроциты: строение, количество, функции, значение
Вопрос 2 Эритроциты: строение, количество, функции, значение
 Вопрос 2. 1 Эритроциты: форма, строение
Вопрос 2. 1 Эритроциты: форма, строение
 Эритроциты: форма, строение • Эритроциты в крови здорового человека преимущественно (до 70 %) имеют форму двояковогнутого диска. • Поверхность диска в 1, 7 раза больше, чем поверхность тела такого же объема, но сферической формы.
Эритроциты: форма, строение • Эритроциты в крови здорового человека преимущественно (до 70 %) имеют форму двояковогнутого диска. • Поверхность диска в 1, 7 раза больше, чем поверхность тела такого же объема, но сферической формы.
 Различные формы эритроцитов, выявляемые при сканирующей электронной микроскопии (× 3600) а, б — дискоцит; в — дискоцит с гребнем; г — дискоцит с множественными выростами; д — эритроцит в виде тутовой ягоды; е — куполообразный эритроцит; ж — сферический эритроцит (гладкий); з — сферический эритроцит с выростами; и — эритроцит в виде спущенного мяча; к — дистрофически измененные эритроциты;
Различные формы эритроцитов, выявляемые при сканирующей электронной микроскопии (× 3600) а, б — дискоцит; в — дискоцит с гребнем; г — дискоцит с множественными выростами; д — эритроцит в виде тутовой ягоды; е — куполообразный эритроцит; ж — сферический эритроцит (гладкий); з — сферический эритроцит с выростами; и — эритроцит в виде спущенного мяча; к — дистрофически измененные эритроциты;

 Пойкилоцитоз • poikilocytosis • наличие в крови эритроцитов разной необычной формы (пойкилоцитов). • Особенно сильно пойкилоцитоз проявляется при миелофиброзе; также он может в той или иной степени
Пойкилоцитоз • poikilocytosis • наличие в крови эритроцитов разной необычной формы (пойкилоцитов). • Особенно сильно пойкилоцитоз проявляется при миелофиброзе; также он может в той или иной степени

 Изменение формы эритроцита при движении
Изменение формы эритроцита при движении
 Изменение формы
Изменение формы

 Эритроцит в капилляре
Эритроцит в капилляре
 Структура мембраны эритроцита
Структура мембраны эритроцита
 Акантоцитоз
Акантоцитоз
 Вопрос 2. 1 Эритроциты: размеры
Вопрос 2. 1 Эритроциты: размеры
 Эритроциты: размеры
Эритроциты: размеры
 В зависимости от диаметра выделяют следующие эритроциты: • • 6 9 мкм – нормоциты менее 6 мкм микроцитами более 9 мкм – макроцитами более 12 мкм – мегалоциты.
В зависимости от диаметра выделяют следующие эритроциты: • • 6 9 мкм – нормоциты менее 6 мкм микроцитами более 9 мкм – макроцитами более 12 мкм – мегалоциты.
 • Микроцитоз – это состояние, когда 30 50% от общего числа эритроцитов составляют микроциты. • Макроцитоз – это состояние, когда 50% и более от общего числа эритроцитов составляют макроциты.
• Микроцитоз – это состояние, когда 30 50% от общего числа эритроцитов составляют микроциты. • Макроцитоз – это состояние, когда 50% и более от общего числа эритроцитов составляют макроциты.
 Charles Price Jones 1865 -1949 • Price Jones C. The variation in the sizes of red blood cells, Brit. med. J. , 11, 1418, 1910.
Charles Price Jones 1865 -1949 • Price Jones C. The variation in the sizes of red blood cells, Brit. med. J. , 11, 1418, 1910.

 Эритроцитометрическая кривая Прайс-Джонса • по оси абсцисс откладывают значение диаметра эритроцитов в микрометрах • по оси ординат процент клеток с соответствующим диаметром.
Эритроцитометрическая кривая Прайс-Джонса • по оси абсцисс откладывают значение диаметра эритроцитов в микрометрах • по оси ординат процент клеток с соответствующим диаметром.
 Эритроцитометрическая кривая • у здоровых людей имеет правильную треугольную форму с высокой вершиной и узким основанием. • Преобладают эритроциты с диаметром 6 8 мкм, которые составляют 70 75% всех эритроцитов. • На долю микроцитов и макроцитов приходится приблизительно одинаковое количество (12 15%), • ширина кривой отражает степень анизоцитоза, а положение максимума средний диаметр эритроцита.
Эритроцитометрическая кривая • у здоровых людей имеет правильную треугольную форму с высокой вершиной и узким основанием. • Преобладают эритроциты с диаметром 6 8 мкм, которые составляют 70 75% всех эритроцитов. • На долю микроцитов и макроцитов приходится приблизительно одинаковое количество (12 15%), • ширина кривой отражает степень анизоцитоза, а положение максимума средний диаметр эритроцита.
 1 – микроцитоз, 2 макроцитоз, 3 – мегалоцитоз, 4 – анизоцитоз на фоне (жёлтом) нормальной кривой Прайс Джонса.
1 – микроцитоз, 2 макроцитоз, 3 – мегалоцитоз, 4 – анизоцитоз на фоне (жёлтом) нормальной кривой Прайс Джонса.
 • При микроцитозе (характерном, например для железодефицитоной анемии) эритроцитометрическая кривая сдвигается влево, кривая становится асимметричной, ширина ее увеличивается. • При макроцитозе (например, сопровождающем В 12 и фолиеводефицитную анемию) кривая Прайс Джонса сдвигается вправо, уплощается, основание ее расширяется. • Построение кривой Прайс Джонса вручную чрезвычайно трудоемкое занятие. • В то же время современные компьютерные системы анализа изображения (например, автоматизированное рабочее место врача гематолога МЕКОС Ц 1) быстро и с высокой точностью строят ее в автоматическом режиме.
• При микроцитозе (характерном, например для железодефицитоной анемии) эритроцитометрическая кривая сдвигается влево, кривая становится асимметричной, ширина ее увеличивается. • При макроцитозе (например, сопровождающем В 12 и фолиеводефицитную анемию) кривая Прайс Джонса сдвигается вправо, уплощается, основание ее расширяется. • Построение кривой Прайс Джонса вручную чрезвычайно трудоемкое занятие. • В то же время современные компьютерные системы анализа изображения (например, автоматизированное рабочее место врача гематолога МЕКОС Ц 1) быстро и с высокой точностью строят ее в автоматическом режиме.
 • Современные проточные гематологические анализаторы тоже автоматически строят сходную кривую, • Вместо диаметра эритроцитов по оси абсцисс откладывается объем эритроцита, поэтому характеристики гистограммы, полученной на проточнике отличаются от таковых классической кривой Прайс Джонса. • Подробно о гистограммах распределения эритроцитов, полученных на автоматических гематологических анализаторах, читайте в статье "Клиническая интерпретация некоторых показателей гематологических анализаторов", которая размещена на сайте по адресу http: //unimedao. ru/knigist 4. htm
• Современные проточные гематологические анализаторы тоже автоматически строят сходную кривую, • Вместо диаметра эритроцитов по оси абсцисс откладывается объем эритроцита, поэтому характеристики гистограммы, полученной на проточнике отличаются от таковых классической кривой Прайс Джонса. • Подробно о гистограммах распределения эритроцитов, полученных на автоматических гематологических анализаторах, читайте в статье "Клиническая интерпретация некоторых показателей гематологических анализаторов", которая размещена на сайте по адресу http: //unimedao. ru/knigist 4. htm
 Анизоцитоз • Anisocytosis • значительное различие в размерах эритроцитов у одного и того же человека. • выявляется с помощью микроскопического исследования мазка крови • симптомом большинства заболеваний крови
Анизоцитоз • Anisocytosis • значительное различие в размерах эритроцитов у одного и того же человека. • выявляется с помощью микроскопического исследования мазка крови • симптомом большинства заболеваний крови
 Присутствие в мазках крови эритроцитов, различающихся по размеру: • с преобладанием эритроцитов малого размера микроанизоцитоз • большого размера макроанизоцитоз
Присутствие в мазках крови эритроцитов, различающихся по размеру: • с преобладанием эритроцитов малого размера микроанизоцитоз • большого размера макроанизоцитоз
 Вопрос 2. 3 Эритроциты: количество
Вопрос 2. 3 Эритроциты: количество
 Количество эритроцитов • у мужчин 4— 5 1012/л, • У женщин – 3, 7 4, 5 1012/л. • При беременности число их может достигать 3, 5 1012/л и даже 3, 2 1012/л .
Количество эритроцитов • у мужчин 4— 5 1012/л, • У женщин – 3, 7 4, 5 1012/л. • При беременности число их может достигать 3, 5 1012/л и даже 3, 2 1012/л .
 Количество эритроцитов • Уменьшение эритропения. • Увеличение эритроцитоз. • Не путайте эритропению с анемией!
Количество эритроцитов • Уменьшение эритропения. • Увеличение эритроцитоз. • Не путайте эритропению с анемией!
 Методики подсчета количества эритроцитов
Методики подсчета количества эритроцитов
 счетчик клеток крови автоматический • • син. : автоанализатор морфологический, гематологический автомат прибор, автоматически подсчитывающий количество клеток крови в единице объема.
счетчик клеток крови автоматический • • син. : автоанализатор морфологический, гематологический автомат прибор, автоматически подсчитывающий количество клеток крови в единице объема.
 Проточные счётчики клеток крови • Кондуктометрический (импедансометрический) метод счета клеток
Проточные счётчики клеток крови • Кондуктометрический (импедансометрический) метод счета клеток
 Анализа тор гематологи ческий
Анализа тор гематологи ческий
 BC 2800 Auto Hematology Analyzer
BC 2800 Auto Hematology Analyzer
 гемоцитометры
гемоцитометры

 Камеры счётные — приборы для подсчета форменных элементов крови, спинномозговой жидкости, а также микроорганизмов. В настоящее время применяют почти исключительно счетную камеру типа Бюркера
Камеры счётные — приборы для подсчета форменных элементов крови, спинномозговой жидкости, а также микроорганизмов. В настоящее время применяют почти исключительно счетную камеру типа Бюркера

 • Подсчитайте количество эритроцитов в малом квадрате камеры Горяева.
• Подсчитайте количество эритроцитов в малом квадрате камеры Горяева.
 • Один из электронных счетчиков частиц был запатентован Coulter в 1957 г. • Он предназначен для счета клеток крови, бактерий, фармакологического контроля эмульсий, вакцин, ферментов и т. п. • Для счета 50 частиц требуется 25 с. • Специальная модель счетчика со щелевым дискриминатором позволяет распределять подсчитываемые частицы по размерам и автоматически регистрировать их число на бумаге с помощью самописца. • Счетчик системы Коултера использовался для счета форменных элементов крови (Urrlich, 1960; Brecher e. a. , 1965).
• Один из электронных счетчиков частиц был запатентован Coulter в 1957 г. • Он предназначен для счета клеток крови, бактерий, фармакологического контроля эмульсий, вакцин, ферментов и т. п. • Для счета 50 частиц требуется 25 с. • Специальная модель счетчика со щелевым дискриминатором позволяет распределять подсчитываемые частицы по размерам и автоматически регистрировать их число на бумаге с помощью самописца. • Счетчик системы Коултера использовался для счета форменных элементов крови (Urrlich, 1960; Brecher e. a. , 1965).
 • Понятие «эритрон» введено английским терапевтом Кастлом для обозначения массы эритроцитов, находящихся в циркулирующей крови, в кровяных депо и костном мозге.
• Понятие «эритрон» введено английским терапевтом Кастлом для обозначения массы эритроцитов, находящихся в циркулирующей крови, в кровяных депо и костном мозге.
 Вопрос 3 Гемоглобин: строение, свойства, количество в крови, методики определения
Вопрос 3 Гемоглобин: строение, свойства, количество в крови, методики определения
 • Основные функции эритроцитов обусловлены наличием в их составе белка хромопротеида — гемоглобина.
• Основные функции эритроцитов обусловлены наличием в их составе белка хромопротеида — гемоглобина.
 Гемоглоби н • от др. греч. αἷμα — кровь и лат. globus — шар • сложный железосодержащий белок эритроцитов животных и человека, способный обратимо связываться с кислородом, обеспечивая его перенос в ткани.
Гемоглоби н • от др. греч. αἷμα — кровь и лат. globus — шар • сложный железосодержащий белок эритроцитов животных и человека, способный обратимо связываться с кислородом, обеспечивая его перенос в ткани.
 В крови здорового человека содержание гемоглобина составляет • 120— 165 г/л • 120— 150 г/л у женщин • 130— 160 г/л у мужчин • У беременных содержание гемоглобина может понижаться до 110 г/л.
В крови здорового человека содержание гемоглобина составляет • 120— 165 г/л • 120— 150 г/л у женщин • 130— 160 г/л у мужчин • У беременных содержание гемоглобина может понижаться до 110 г/л.
 Основные функции гемоглобина: • транспорт О 2 и СО 2 (дыхательных газов) • буфер • связывание токсичных веществ
Основные функции гемоглобина: • транспорт О 2 и СО 2 (дыхательных газов) • буфер • связывание токсичных веществ
 Виды гемоглобина в зависимости от состояния гема и глобина: • оксигемоглобин (НЬО 2) • дезоксигемоглобин (ННb) • метгемоглобин (Met. Hb) • карбгемоглобин (Нb. СО 2) • карбоксигемоглобин (Нb. СО)
Виды гемоглобина в зависимости от состояния гема и глобина: • оксигемоглобин (НЬО 2) • дезоксигемоглобин (ННb) • метгемоглобин (Met. Hb) • карбгемоглобин (Нb. СО 2) • карбоксигемоглобин (Нb. СО)
 Виды гемоглобина в зависимости от состояния гема и глобина: • оксигемоглобин (НЬО 2) — присоединивший четыре молекулы О 2 (в артериальной крови 98 %, в венозной 65 %). • дезоксигемоглобин (ННb)— гемоглобин, отдавший кислород (в артериальной крови ~2 %, в венозной 35 %); • метгемоглобин (Met. Hb) — имеет окисленные атомы железа (Fe 3+), не присоединяющие О 2 (в норме менее 3 %). • карбгемоглобин (Нb. СО 2) — присоединяет СО 2 к глобину (находится в венозной крови); • карбоксигемоглобин (Нb. СО) — СО имеет сродство к Нb в 240 раз выше, чем О 2, и блокирует присоединение О 2 (например, если в крови Рсо = 0, 5 мм рт. ст. , то 50 % гемоглобина будет связано с СО);
Виды гемоглобина в зависимости от состояния гема и глобина: • оксигемоглобин (НЬО 2) — присоединивший четыре молекулы О 2 (в артериальной крови 98 %, в венозной 65 %). • дезоксигемоглобин (ННb)— гемоглобин, отдавший кислород (в артериальной крови ~2 %, в венозной 35 %); • метгемоглобин (Met. Hb) — имеет окисленные атомы железа (Fe 3+), не присоединяющие О 2 (в норме менее 3 %). • карбгемоглобин (Нb. СО 2) — присоединяет СО 2 к глобину (находится в венозной крови); • карбоксигемоглобин (Нb. СО) — СО имеет сродство к Нb в 240 раз выше, чем О 2, и блокирует присоединение О 2 (например, если в крови Рсо = 0, 5 мм рт. ст. , то 50 % гемоглобина будет связано с СО);
 • Набор контрольных растворов гемоглобина предназначен проведения контроля правильности и воспроизводимости результатов определения концентрации гемоглобина в крови унифицированным гемиглобинцианидным методом и гемихромным методом.
• Набор контрольных растворов гемоглобина предназначен проведения контроля правильности и воспроизводимости результатов определения концентрации гемоглобина в крови унифицированным гемиглобинцианидным методом и гемихромным методом.
 • Гемометр Сали
• Гемометр Сали
 Вопрос 4 Кривая диссоциация оксигемоглобина
Вопрос 4 Кривая диссоциация оксигемоглобина
 КРИВАЯ ДИССОЦИАЦИИ ОКСИГЕМОГЛОБИНА • oxygen hemoglobin dissociation curve • это график зависимости насыщения гемоглобина кислородом (в относительных единицах от максимальных значений) от напряжения кислорода в плазме крови
КРИВАЯ ДИССОЦИАЦИИ ОКСИГЕМОГЛОБИНА • oxygen hemoglobin dissociation curve • это график зависимости насыщения гемоглобина кислородом (в относительных единицах от максимальных значений) от напряжения кислорода в плазме крови

 1 – миоглобин 2 – F-гемоглобин 3 – А-гемоглобин
1 – миоглобин 2 – F-гемоглобин 3 – А-гемоглобин

 Вопрос 5 Cодержание гемоглобина в эритроцитах
Вопрос 5 Cодержание гемоглобина в эритроцитах
 Cодержание в эритроцитах гемоглобина отражают • Цветовой показатель (фарб-индекс) • Среднее содержание гемоглобина в эритроците
Cодержание в эритроцитах гемоглобина отражают • Цветовой показатель (фарб-индекс) • Среднее содержание гемоглобина в эритроците
 Цветовой показатель (фарб-индекс) • Fi — это соотношение гемоглобина и эритроцитов, выраженных в относительных единицах; • 100 % гемоглобина 166, 7 г/л • 100 % эритроцитов 5 1012/л • Если у человека содержание гемоглобина и эритроцитов равно 100 %, то цветовой показатель равен 1.
Цветовой показатель (фарб-индекс) • Fi — это соотношение гемоглобина и эритроцитов, выраженных в относительных единицах; • 100 % гемоглобина 166, 7 г/л • 100 % эритроцитов 5 1012/л • Если у человека содержание гемоглобина и эритроцитов равно 100 %, то цветовой показатель равен 1.
 • Часто цветовой показатель определяют путем деления утроенного числа граммов гемоглобина на три первые цифры числа эритроцитов.
• Часто цветовой показатель определяют путем деления утроенного числа граммов гемоглобина на три первые цифры числа эритроцитов.
 эритроциты • Нормохромные Fi = 0, 7 1, 1 • Гипохромные Fi менее 0, 7 • Гиперхромные Fi более 1, 1 • Гиперхромные эритроциты увеличиваются в размерах
эритроциты • Нормохромные Fi = 0, 7 1, 1 • Гипохромные Fi менее 0, 7 • Гиперхромные Fi более 1, 1 • Гиперхромные эритроциты увеличиваются в размерах
 Среднее содержание гемоглобина в отдельном эритроците • MCH (mean corpuscular hemoglobin) • среднее содержание гемоглобина — в абсолютных единицах (норма 27— 31 пг). • MCH — более объективный показатель, чем цветовой показатель
Среднее содержание гемоглобина в отдельном эритроците • MCH (mean corpuscular hemoglobin) • среднее содержание гемоглобина — в абсолютных единицах (норма 27— 31 пг). • MCH — более объективный показатель, чем цветовой показатель
 Вопрос 6 Лейкоциты: виды, количество, методики подсчета
Вопрос 6 Лейкоциты: виды, количество, методики подсчета
 Вопрос 6. 1 Лейкоциты: виды
Вопрос 6. 1 Лейкоциты: виды
 Лейкоциты: виды • Гранулоциты • Агранулоциты
Лейкоциты: виды • Гранулоциты • Агранулоциты

Экспресс-анализатор крови • • Исследователи из Калифорнийского технологического института, Калифорнийского университета и компании IRIS International разработали портативный анализатор крови, который будет выполнять точный анализ всего за 2 минуты. Предполагается, что прибор анализатор будет востребован при пилотируемых миссиях на Марс или Луну. Новое устройство размером с мобильный телефон может всего лишь по одной капле крови выдать ее полноценный анализ. Разработка портативного анализатора проводилась специалистами из Калифорнийского университета, США, в рамках программы Национального исследовательского института биомедицинских космических приложений (National Space Biomedical Research Institute NSBRI), сообщает Eurek. Alert.
Экспресс-анализатор крови • • Исследователи из Калифорнийского технологического института, Калифорнийского университета и компании IRIS International разработали портативный анализатор крови, который будет выполнять точный анализ всего за 2 минуты. Предполагается, что прибор анализатор будет востребован при пилотируемых миссиях на Марс или Луну. Новое устройство размером с мобильный телефон может всего лишь по одной капле крови выдать ее полноценный анализ. Разработка портативного анализатора проводилась специалистами из Калифорнийского университета, США, в рамках программы Национального исследовательского института биомедицинских космических приложений (National Space Biomedical Research Institute NSBRI), сообщает Eurek. Alert.
 Вопрос 7 Лейкоцитарная формула
Вопрос 7 Лейкоцитарная формула
 Лейкоцитарная формула (лейкограмма) — процентное соотношение различных видов лейкоцитов, определяемое при подсчёте их в окрашенном мазке крови под микроскопом.
Лейкоцитарная формула (лейкограмма) — процентное соотношение различных видов лейкоцитов, определяемое при подсчёте их в окрашенном мазке крови под микроскопом.
 Нормальная лейкограмма
Нормальная лейкограмма
 Нормальная лейкограмма ? • • Ю 0 П – 1 С – 50 Э – 4 Б – 1 М – 4 Л – 20
Нормальная лейкограмма ? • • Ю 0 П – 1 С – 50 Э – 4 Б – 1 М – 4 Л – 20
 Нормальная лейкограмма • • Ю 0 П – 1 С – 50 Э – 4 Б – 1 М – 4 Л – 20 Сумма – 80 % ? ? ?
Нормальная лейкограмма • • Ю 0 П – 1 С – 50 Э – 4 Б – 1 М – 4 Л – 20 Сумма – 80 % ? ? ?


 Сдвиг лейкоцитарной формулы Влево — увеличение количества незрелых (палочкоядерных) нейтрофилов в периферической крови, появление метамиелоцитов (юных), миелоцитов; Вправо — уменьшение нормального количества палочкоядерных нейтрофилов и увеличение числа сегментоядерных нейтрофилов с гиперсегментированными ядрами.
Сдвиг лейкоцитарной формулы Влево — увеличение количества незрелых (палочкоядерных) нейтрофилов в периферической крови, появление метамиелоцитов (юных), миелоцитов; Вправо — уменьшение нормального количества палочкоядерных нейтрофилов и увеличение числа сегментоядерных нейтрофилов с гиперсегментированными ядрами.
 Вопрос 9 Понятие «группы крови»
Вопрос 9 Понятие «группы крови»
 Гру ппа кро ви • описание индивидуальных антигенных характеристик эритроцитов, определяемое с помощью методов идентификации специфических групп углеводов и белков, включённых в мембраны эритроцитов человека и животных.
Гру ппа кро ви • описание индивидуальных антигенных характеристик эритроцитов, определяемое с помощью методов идентификации специфических групп углеводов и белков, включённых в мембраны эритроцитов человека и животных.
 • Открытие групп крови тесно связано с решением проблемы практической медицины – неудачами при использовании переливания крови (гемотрансфузии) для лечения больных. • Причём редкие успехи (30%) чередовались с частыми неудачами (70%)
• Открытие групп крови тесно связано с решением проблемы практической медицины – неудачами при использовании переливания крови (гемотрансфузии) для лечения больных. • Причём редкие успехи (30%) чередовались с частыми неудачами (70%)
 В 1667 г. во Франции врачами Дени и Эммерезом было произведено первое в истории человечества внутривенное переливание крови человеку. • Обескровленному умирающему юноше перелили кровь ягненка. Первое переливание случайно оказалось удачным. Хотя чужеродная кровь и вызвала тяжелую реакцию, больной перенес ее и выздоровел. • Успех окрылил ученых. Они стали переливать кровь животных другим больным. Однако последующие попытки были неудачными: больные погибали. • Родственники умерших возбудили против врачей судебный процесс, и переливания крови были запрещены законом.
В 1667 г. во Франции врачами Дени и Эммерезом было произведено первое в истории человечества внутривенное переливание крови человеку. • Обескровленному умирающему юноше перелили кровь ягненка. Первое переливание случайно оказалось удачным. Хотя чужеродная кровь и вызвала тяжелую реакцию, больной перенес ее и выздоровел. • Успех окрылил ученых. Они стали переливать кровь животных другим больным. Однако последующие попытки были неудачными: больные погибали. • Родственники умерших возбудили против врачей судебный процесс, и переливания крови были запрещены законом.
 Попытки переливания крови от животных в кровяное русло человека оканчивались, как правило, неудачей.
Попытки переливания крови от животных в кровяное русло человека оканчивались, как правило, неудачей.
 • Попытки произвести переливание крови возобновились в конце XVIII в. • Неудачи переливания гетерогенной крови привели к мысли о возможности переливания только человеческой крови. • В 1819 году английский физиолог и акушер Бланделл произвел первое переливание крови от человека человеку и предложил специальный аппарат для гемотрансфузии.
• Попытки произвести переливание крови возобновились в конце XVIII в. • Неудачи переливания гетерогенной крови привели к мысли о возможности переливания только человеческой крови. • В 1819 году английский физиолог и акушер Бланделл произвел первое переливание крови от человека человеку и предложил специальный аппарат для гемотрансфузии.
 • В отечественной литературе первые предложения переливания крови больным появились в работах профессора Кронштадтского врачебного училища Матвея Пэкэна (1787) и профессора медико хирургической академии в Петербурге С. Ф. Хотовицкого (1830). • В 1832 г. Г. Вольф перелил кровь женщине, умиравшей после родов от маточного кровотечения, что привело к полному выздоровлению больной.
• В отечественной литературе первые предложения переливания крови больным появились в работах профессора Кронштадтского врачебного училища Матвея Пэкэна (1787) и профессора медико хирургической академии в Петербурге С. Ф. Хотовицкого (1830). • В 1832 г. Г. Вольф перелил кровь женщине, умиравшей после родов от маточного кровотечения, что привело к полному выздоровлению больной.
 • В России первым фундаментальным трудом по переливанию крови явилась книга А. М. Филомафитского «Трактат о переливании крови как единственном средстве во многих случаях спасти угасающую жизнь, составленный в историческом, физиологическом и хирургическом отношениях…. » (1848).
• В России первым фундаментальным трудом по переливанию крови явилась книга А. М. Филомафитского «Трактат о переливании крови как единственном средстве во многих случаях спасти угасающую жизнь, составленный в историческом, физиологическом и хирургическом отношениях…. » (1848).
 В 1901 году австрийский медик Карл Ландштейнер открыл явление агглютинации (склеивания) эритроцитов, как защитной реакции крови на введение в организм «чужих» эритроцитов. • И сегодня мы рассматриваем явление агглютинации как проявление защитной функции крови (специфического гуморального иммунитета).
В 1901 году австрийский медик Карл Ландштейнер открыл явление агглютинации (склеивания) эритроцитов, как защитной реакции крови на введение в организм «чужих» эритроцитов. • И сегодня мы рассматриваем явление агглютинации как проявление защитной функции крови (специфического гуморального иммунитета).
 Карл Ла ндштейнер • Karl Landsteiner • 1868 — 1943 • австрийский врач, химик, иммунолог, инфекционист. • Первый исследователь в области иммуногематологии и иммунохимии, автор трудов по молекулярной и клеточной физиологии реакции организма на размытые антигены и возникающие при этом специфические и неспецифические явления. • Лауреат Нобелевской премии по физиологии и медицине (1930).
Карл Ла ндштейнер • Karl Landsteiner • 1868 — 1943 • австрийский врач, химик, иммунолог, инфекционист. • Первый исследователь в области иммуногематологии и иммунохимии, автор трудов по молекулярной и клеточной физиологии реакции организма на размытые антигены и возникающие при этом специфические и неспецифические явления. • Лауреат Нобелевской премии по физиологии и медицине (1930).
 Агглютинация • склеивание и выпадение в осадок из однородной взвеси бактерий, эритроцитов и др. клеток, несущих антигены, под действием специфических веществ — агглютининов, в роли которых могут, например, выступать антитела или лектины. • Реакцию агглютинации применяют для определения групп крови, идентификации возбудителей инфекционных заболеваний и др.
Агглютинация • склеивание и выпадение в осадок из однородной взвеси бактерий, эритроцитов и др. клеток, несущих антигены, под действием специфических веществ — агглютининов, в роли которых могут, например, выступать антитела или лектины. • Реакцию агглютинации применяют для определения групп крови, идентификации возбудителей инфекционных заболеваний и др.
 Агглютинация
Агглютинация
 • В основе агглютинации лежит наличие на поверхности эритроцитов антигенов, названных агглютиногенами, а в плазме — антител, или агглютининов. • Агглютинация эритроцитов наблюдается лишь в том случае, если встречаются одноименные агглютиноген и агглютинин (например А и , В и . • Поэтому это явление было названо изогемагглютинация.
• В основе агглютинации лежит наличие на поверхности эритроцитов антигенов, названных агглютиногенами, а в плазме — антител, или агглютининов. • Агглютинация эритроцитов наблюдается лишь в том случае, если встречаются одноименные агглютиноген и агглютинин (например А и , В и . • Поэтому это явление было названо изогемагглютинация.
 • В то же время К. Ландштейнер показал терпимость (толерантность) крови реципиента к крови некоторых доноров. • Поэтому К. Ландштейнер стал одним из тех «гигантов, на плечах которых стоял» Питер Медавар – создатель учения об иммунологической толерантности.
• В то же время К. Ландштейнер показал терпимость (толерантность) крови реципиента к крови некоторых доноров. • Поэтому К. Ландштейнер стал одним из тех «гигантов, на плечах которых стоял» Питер Медавар – создатель учения об иммунологической толерантности.
 К. Ландштейнер разделил всех людей на 3 группы: • имеющих на эритроцитах антиген A, • имеющих на эритроцитах антиген B, • не имеющих на эритроцитах ни антигена A ни антигена B т. е. разработал системы групп крови АВ 0, за был удостоен Нобелевской премии. в 1930 году. На основании определения групп крови по системе АВ 0 были сформулированы основные правила переливания крови у человека.
К. Ландштейнер разделил всех людей на 3 группы: • имеющих на эритроцитах антиген A, • имеющих на эритроцитах антиген B, • не имеющих на эритроцитах ни антигена A ни антигена B т. е. разработал системы групп крови АВ 0, за был удостоен Нобелевской премии. в 1930 году. На основании определения групп крови по системе АВ 0 были сформулированы основные правила переливания крови у человека.
 • В 1907 г. Я Янский и в 1910 г. Мосс выделили четвертую группу крови. • Амер. хирург Дж. Крайл (1907) первый применил учение о группах крови в практике переливания крови.
• В 1907 г. Я Янский и в 1910 г. Мосс выделили четвертую группу крови. • Амер. хирург Дж. Крайл (1907) первый применил учение о группах крови в практике переливания крови.
 • Согласно современным представлениям, мембрана эритроцита рассматривается как набор самых различных антигенов, которых насчитывается более 500. • Только из этих антигенов можно составить более 400 млн комбинаций, или групповых признаков крови. • Если же учитывать и все остальные антигены, встречающиеся в крови, то число комбинаций достигнет 700 млрд.
• Согласно современным представлениям, мембрана эритроцита рассматривается как набор самых различных антигенов, которых насчитывается более 500. • Только из этих антигенов можно составить более 400 млн комбинаций, или групповых признаков крови. • Если же учитывать и все остальные антигены, встречающиеся в крови, то число комбинаций достигнет 700 млрд.
 Но когда врач говорит о «группе крови» , он имеет в виду 2 системы (комбинации): • АВ 0 • Резус (Rh)
Но когда врач говорит о «группе крови» , он имеет в виду 2 системы (комбинации): • АВ 0 • Резус (Rh)
 О системах • Kell (группы: К, — группа Келл, К 2 — группа Келлано и К, К 2 — группа Келл—Келлано), • MNSs (группы: MS, NS, Ms, Ns, MNs), • Лютеран (группы: Lu(a+), Lu(b+), Lu(a+b+), Lu(a+b"), Lu(a~b+), Lu(a~b") и др) читайте Учебник 2003 г. С. 259.
О системах • Kell (группы: К, — группа Келл, К 2 — группа Келлано и К, К 2 — группа Келл—Келлано), • MNSs (группы: MS, NS, Ms, Ns, MNs), • Лютеран (группы: Lu(a+), Lu(b+), Lu(a+b+), Lu(a+b"), Lu(a~b+), Lu(a~b") и др) читайте Учебник 2003 г. С. 259.
 Кровь доноров исследуют по системам • АВ 0 • Резус (Rh) • Kell
Кровь доноров исследуют по системам • АВ 0 • Резус (Rh) • Kell
 • Агглютинины имеют два центра связывания, а потому одна молекула агглютинина способна образовать мостик между двумя эритроцитами. • При этом каждый из эритроцитов может при участии агглютининов связаться с соседним, благодаря чему возникает конгломерат (агглютинат) эритроцитов.
• Агглютинины имеют два центра связывания, а потому одна молекула агглютинина способна образовать мостик между двумя эритроцитами. • При этом каждый из эритроцитов может при участии агглютининов связаться с соседним, благодаря чему возникает конгломерат (агглютинат) эритроцитов.
 • В крови одного и того же человека не может быть одноименных агглютиногенов и агглютининов, так как в противном случае происходило бы массовое склеивание эритроцитов, что несовместимо с жизнью.
• В крови одного и того же человека не может быть одноименных агглютиногенов и агглютининов, так как в противном случае происходило бы массовое склеивание эритроцитов, что несовместимо с жизнью.
 Вопрос 10 Система групп крови AB 0
Вопрос 10 Система групп крови AB 0
 • Рис. 711300511. Строение гликолипидов мембран эритроцитов, определяющих группу крови человека.
• Рис. 711300511. Строение гликолипидов мембран эритроцитов, определяющих группу крови человека.
 Строение гликолипидов мембран эритроцитов, определяющих группу крови человека.
Строение гликолипидов мембран эритроцитов, определяющих группу крови человека.
 Варианты агглютиногенов системы АВ 0 • Агглютиногены А и В существуют в разных вариантах, различающихся по своему строению и антигенной активности. • Большинство из этих агглютиногенов получило цифровое обозначение (А 1, А 2, А 3 и т. д. , В 1, В 2 и т. д. ). Чем больше порядковый номер агглютиногена, тем меньшую активность он проявляет.
Варианты агглютиногенов системы АВ 0 • Агглютиногены А и В существуют в разных вариантах, различающихся по своему строению и антигенной активности. • Большинство из этих агглютиногенов получило цифровое обозначение (А 1, А 2, А 3 и т. д. , В 1, В 2 и т. д. ). Чем больше порядковый номер агглютиногена, тем меньшую активность он проявляет.
 Агглютинины системы АВ 0 • Тип антител системы АВ 0 • Большая часть антител системы АВ 0 относится к типу Ig. M. • Обладая 10 участками связывания антигенов, они представляют собой полные антитела, способные вызывать агглютинацию эритроцитов.
Агглютинины системы АВ 0 • Тип антител системы АВ 0 • Большая часть антител системы АВ 0 относится к типу Ig. M. • Обладая 10 участками связывания антигенов, они представляют собой полные антитела, способные вызывать агглютинацию эритроцитов.
 Когда появляются антитела ? • В крови новорожденных, как правило, нет антител системы АВ 0. • В течение первого года жизни у ребенка образуются антитела к тем антигенам, которых нет в его собственных эритроцитах. • Продукция этих антител, возможно, вызывается веществами, поступающими с пищей или вырабатываемыми кишечной микрофлорой. • В настоящее время выяснено, что в кишечнике присутствуют бактерии, несущие те же антигенные детерминанты, что и эритроциты
Когда появляются антитела ? • В крови новорожденных, как правило, нет антител системы АВ 0. • В течение первого года жизни у ребенка образуются антитела к тем антигенам, которых нет в его собственных эритроцитах. • Продукция этих антител, возможно, вызывается веществами, поступающими с пищей или вырабатываемыми кишечной микрофлорой. • В настоящее время выяснено, что в кишечнике присутствуют бактерии, несущие те же антигенные детерминанты, что и эритроциты
 Гемолизины системы АВ 0 • Кроме агглютининов, в плазме крови содержатся гемолизины. Их также два вида, и они обозначаются, как и агглютинины, буквами и. • При встрече одноименных агглютиногена и гемолизина наступает гемолиз эритроцитов. • Действие гемолизинов проявляется при температуре 37 40 °С. Вот почему при переливании несовместимой крови у человека уже через 30— 40 с наступает гемолиз эритроцитов. • При комнатной температу ре, если встречаются одноименные агглютиногены и агглютинины, происхо дит агглютинация, но не гемолиз.
Гемолизины системы АВ 0 • Кроме агглютининов, в плазме крови содержатся гемолизины. Их также два вида, и они обозначаются, как и агглютинины, буквами и. • При встрече одноименных агглютиногена и гемолизина наступает гемолиз эритроцитов. • Действие гемолизинов проявляется при температуре 37 40 °С. Вот почему при переливании несовместимой крови у человека уже через 30— 40 с наступает гемолиз эритроцитов. • При комнатной температу ре, если встречаются одноименные агглютиногены и агглютинины, происхо дит агглютинация, но не гемолиз.
 • Развитие ДВС синдрома при переливании несовместимой крови
• Развитие ДВС синдрома при переливании несовместимой крови
 Группы крови и заболеваемость • Люди, имеющие различные группы крови, в неодинаковой мере подвержены тем или иным заболеваниям. Так, у людей с I(0) группой крови чаще встречается язвенная болезнь желудка и двенадцатиперстной кишки. • Люди, имеющие II(А) группу крови, чаще страдают и тяжелее переносят сахарный диабет; у них повышена свертываемость крови.
Группы крови и заболеваемость • Люди, имеющие различные группы крови, в неодинаковой мере подвержены тем или иным заболеваниям. Так, у людей с I(0) группой крови чаще встречается язвенная болезнь желудка и двенадцатиперстной кишки. • Люди, имеющие II(А) группу крови, чаще страдают и тяжелее переносят сахарный диабет; у них повышена свертываемость крови.
 К вопросу о «питании по группам крови»
К вопросу о «питании по группам крови»
 К вопросу об «универсальных донорах и реципиентах»
К вопросу об «универсальных донорах и реципиентах»
 К вопросу об «универсальных донорах и реципиентах» • Ранее люди с группой крови О считались «универсальными донорами» , и их кровь переливали лицам любых других групп. • В настоящее время подобные гемотрансфузии считаются недопустимыми. • Антигены А и В в эритроцитах группы О отсутствуют или находятся в пренебрежимо малых количествах, поэтому практически любой объем этих эритроцитов можно без опасений переливать реципиентам других групп крови. Однако в плазме группы О содержатся агглютини ны анти А и анти В, и эту плазму можно вводить лишь в ограниченном объеме. При переливаниях больших коли честв агглютинины донора уже не разводятся плазмой реципиента, и наступает агглютинация.
К вопросу об «универсальных донорах и реципиентах» • Ранее люди с группой крови О считались «универсальными донорами» , и их кровь переливали лицам любых других групп. • В настоящее время подобные гемотрансфузии считаются недопустимыми. • Антигены А и В в эритроцитах группы О отсутствуют или находятся в пренебрежимо малых количествах, поэтому практически любой объем этих эритроцитов можно без опасений переливать реципиентам других групп крови. Однако в плазме группы О содержатся агглютини ны анти А и анти В, и эту плазму можно вводить лишь в ограниченном объеме. При переливаниях больших коли честв агглютинины донора уже не разводятся плазмой реципиента, и наступает агглютинация.




 Вопрос 11 Определение групп крови системы AB 0
Вопрос 11 Определение групп крови системы AB 0
 Цоликло н • солевой раствор моноклональных антител к антигенам эритроцитов человека, расположенных на поверхности. • Моноклональные тела для цоликлонов получают при помощи определенных штаммов бактерий. • Бактерии для таких производств получают методами генной инженерии.
Цоликло н • солевой раствор моноклональных антител к антигенам эритроцитов человека, расположенных на поверхности. • Моноклональные тела для цоликлонов получают при помощи определенных штаммов бактерий. • Бактерии для таких производств получают методами генной инженерии.
 Моноклональные антитела • антитела, вырабатываемые иммунными клетками, принадлежащими к одному клеточному клону, то есть произошедшими из одной плазматической клетки предшественницы.
Моноклональные антитела • антитела, вырабатываемые иммунными клетками, принадлежащими к одному клеточному клону, то есть произошедшими из одной плазматической клетки предшественницы.
 Характеристика и основные свойства Цоликлонов Анти-А, Анти-В и Анти-АВ • Моноклональные Анти А и Анти В антитела продуцируются двумя мышиными гибридомами и принадлежат к иммуноглобулинам класса М • Цоликпоны изготавливаются из асцитной жидкости мышей носителей анти А и анти В гибридом • Цоликлон Анти АВ представляет собой смесь моноклональных анти А и анти В антител.
Характеристика и основные свойства Цоликлонов Анти-А, Анти-В и Анти-АВ • Моноклональные Анти А и Анти В антитела продуцируются двумя мышиными гибридомами и принадлежат к иммуноглобулинам класса М • Цоликпоны изготавливаются из асцитной жидкости мышей носителей анти А и анти В гибридом • Цоликлон Анти АВ представляет собой смесь моноклональных анти А и анти В антител.

 Планшет П 50 • Габариты: 190× 290 мм Упаковка: 100 шт • Оптовая цена: 26 руб. /шт. • Розничная цена: 33 руб. /шт
Планшет П 50 • Габариты: 190× 290 мм Упаковка: 100 шт • Оптовая цена: 26 руб. /шт. • Розничная цена: 33 руб. /шт
 Цоликлоны • моноклональные антитела к антигенам эритроцитов человека системы АВО и Резус, • моноспецифичны
Цоликлоны • моноклональные антитела к антигенам эритроцитов человека системы АВО и Резус, • моноспецифичны


 Цоликлоны анти-А, анти-В и анти-АВ • моноклональные антитела к А антигенам и В антигенам эритроцитов человека системы АВО, моноспецифичны. • Препараты представляют собой солевые растворы полных антител изотопа Ig. M, стабилизированы азидом натрия. • Окрашены: анти А в розовый цветфеноловым красным, анти В в синий цвет трепановым синим, анти АВ бесцветный. • Применяются для типирования крови человека по системе АВО в реакции прямой агглютинации на плоскости, в пробирке и в микроплате. • Агглютинация эритроцитов в присутствии одного из реагентов (положительная реакция) свидетельствует о наличии в исследуемой крови соответствующего антигена. • Срок годности реагентов 2 года при температуре хранения от +2 до +8 град. С.
Цоликлоны анти-А, анти-В и анти-АВ • моноклональные антитела к А антигенам и В антигенам эритроцитов человека системы АВО, моноспецифичны. • Препараты представляют собой солевые растворы полных антител изотопа Ig. M, стабилизированы азидом натрия. • Окрашены: анти А в розовый цветфеноловым красным, анти В в синий цвет трепановым синим, анти АВ бесцветный. • Применяются для типирования крови человека по системе АВО в реакции прямой агглютинации на плоскости, в пробирке и в микроплате. • Агглютинация эритроцитов в присутствии одного из реагентов (положительная реакция) свидетельствует о наличии в исследуемой крови соответствующего антигена. • Срок годности реагентов 2 года при температуре хранения от +2 до +8 град. С.
 Планшеты для типирования крови • Металлические эмалированые планшеты, 7 х10 лунок с буквенно цифровой кодификацией. • Многократного применения. • Методы стерилизации и дезинфекции сухожаровая обработка, автоклавирование, обработка дез. средствами.
Планшеты для типирования крови • Металлические эмалированые планшеты, 7 х10 лунок с буквенно цифровой кодификацией. • Многократного применения. • Методы стерилизации и дезинфекции сухожаровая обработка, автоклавирование, обработка дез. средствами.
 Стандартные сыворотки
Стандартные сыворотки
 • Стандартные эритроциты для определения группы крови. Набор: А 1 В Количество: 2 х10 мл
• Стандартные эритроциты для определения группы крови. Набор: А 1 В Количество: 2 х10 мл
 Отмытые стандартные эритроциты
Отмытые стандартные эритроциты
 Какая группа крови у Иису са Христа? Туринская плащаница • Согласно проведенной экспертизе Туринской плащаницы, следы крови на ней относятся к группе AB(IV) Rh+. [ • Эта же группа крови обнаружена на Сударе (Sudarium) погребальном полотне, которым была обернута голова Христа при снятии с креста.
Какая группа крови у Иису са Христа? Туринская плащаница • Согласно проведенной экспертизе Туринской плащаницы, следы крови на ней относятся к группе AB(IV) Rh+. [ • Эта же группа крови обнаружена на Сударе (Sudarium) погребальном полотне, которым была обернута голова Христа при снятии с креста.
 Вопрос 12 Система резус (Rh-hr)
Вопрос 12 Система резус (Rh-hr)
 • Макака резус • В конце 30 х годов прошлого столетия Ландштейнер и Винер, сравнивая антигенные свойства эритроцитов человека и обезьян, обнаружили, что у большинства людей имеется антиген, аналогичный обезьяньему. • Ученые назвали его резусфактором (Rh). • Всего 10 15% людей в мире не имеют этого антигена, то есть у них резус отрицательный.
• Макака резус • В конце 30 х годов прошлого столетия Ландштейнер и Винер, сравнивая антигенные свойства эритроцитов человека и обезьян, обнаружили, что у большинства людей имеется антиген, аналогичный обезьяньему. • Ученые назвали его резусфактором (Rh). • Всего 10 15% людей в мире не имеют этого антигена, то есть у них резус отрицательный.
 • Взаимодействие эритроцитов с сывороткой анти Rh обусловлено наличием в разных участках мембраны нескольких антигенов (неполные антигены). • Важнейшие из этих антигенов С, D, Е, с и е; наиболее выражены антигенные свойства у агглютиногена D. • Для простоты кровь, содержащую D эритроциты, называют резусположительной (Rh+ , или Rh), а кровь без таких эритроцитов резус-отрицательной (Rh , или rh).
• Взаимодействие эритроцитов с сывороткой анти Rh обусловлено наличием в разных участках мембраны нескольких антигенов (неполные антигены). • Важнейшие из этих антигенов С, D, Е, с и е; наиболее выражены антигенные свойства у агглютиногена D. • Для простоты кровь, содержащую D эритроциты, называют резусположительной (Rh+ , или Rh), а кровь без таких эритроцитов резус-отрицательной (Rh , или rh).
 Различия между системами Rh и АВ 0 • АВ 0 агглютинины всегда содержатся в крови человека уже после первых месяцев жизни • Rh агглютинины появляются только после сенсибилизации контакта rh индивида с Rh антигенами.
Различия между системами Rh и АВ 0 • АВ 0 агглютинины всегда содержатся в крови человека уже после первых месяцев жизни • Rh агглютинины появляются только после сенсибилизации контакта rh индивида с Rh антигенами.
 Различия между системами Rh и АВ 0 • При первом контакте rh индивида с Rh антигенами явной реакции обычно не возникает. • Реакции антиген антитело появляются только при повторном контакте rh индивида с Rh антигенами
Различия между системами Rh и АВ 0 • При первом контакте rh индивида с Rh антигенами явной реакции обычно не возникает. • Реакции антиген антитело появляются только при повторном контакте rh индивида с Rh антигенами

 Различия между системами Rh и АВ 0 • Большинство Rh агглютининов представляет собой неполные антитела Ig. G, проникают через плацентарный барьер. • Большинство АВ 0 агглютининов представляет собой полные антитела Ig. М, не проникают через плацентарный барьер.
Различия между системами Rh и АВ 0 • Большинство Rh агглютининов представляет собой неполные антитела Ig. G, проникают через плацентарный барьер. • Большинство АВ 0 агглютининов представляет собой полные антитела Ig. М, не проникают через плацентарный барьер.
 Вопрос 13 Резус-несовместимость и беременность
Вопрос 13 Резус-несовместимость и беременность



 Анти-D-профилактика • Образование антител в организме Rh женщины можно ограничить или полностью подавить путем так называемой анти-Dпрофилактики. • Если непосредственно после родов (в том числе преждевременных) женщине ввести aнти D глобулин, то Rh+ эритроциты, проникшие в её кровь, разрушатся и тем самым будет ликвидирован фактор, вызывающий выработку антител иммунной системой.
Анти-D-профилактика • Образование антител в организме Rh женщины можно ограничить или полностью подавить путем так называемой анти-Dпрофилактики. • Если непосредственно после родов (в том числе преждевременных) женщине ввести aнти D глобулин, то Rh+ эритроциты, проникшие в её кровь, разрушатся и тем самым будет ликвидирован фактор, вызывающий выработку антител иммунной системой.
 Бэй. Роу-Ди • Препараты анти резус иммуноглобулина человека начали применять более 30 лет назад. В последние годы на Российском рынке появился самый эффективный среди анти резус иммуноглобулинов немецкий препарат фирмы Байер Бэй Роу ди. Он достаточно дорог, но впереди счастье иметь здорового ребенка. краткие показания • профилактика резус конфликта • особые • примечанияпре парат продается по 1 й ампуле Показания • профилактика изоиммунизаци и при аборте, • внематочной беременности, • при нормальной беременности у женщин с отрицательным резус фактором, • при переливании крови. • дозировкапров одится в условиях стационара, дозировка, способ и срок введения определяется показаниями
Бэй. Роу-Ди • Препараты анти резус иммуноглобулина человека начали применять более 30 лет назад. В последние годы на Российском рынке появился самый эффективный среди анти резус иммуноглобулинов немецкий препарат фирмы Байер Бэй Роу ди. Он достаточно дорог, но впереди счастье иметь здорового ребенка. краткие показания • профилактика резус конфликта • особые • примечанияпре парат продается по 1 й ампуле Показания • профилактика изоиммунизаци и при аборте, • внематочной беременности, • при нормальной беременности у женщин с отрицательным резус фактором, • при переливании крови. • дозировкапров одится в условиях стационара, дозировка, способ и срок введения определяется показаниями
 Несовместимость матери и плода по системе АВ 0 • Большинство Rh агглютининов представляет собой неполные антитела Ig. G, размеры которых в отличие от размеров полных агглютининов системы АВ 0 достаточно малы, чтобы они могли проникать через плацентарный барьер. • Реакции антиген антитело могут возникать и при несовместимости матери и плода по другим групповым признакам (в частности, АВ 0), однако такие реакции обычно бывают слабо выражены.
Несовместимость матери и плода по системе АВ 0 • Большинство Rh агглютининов представляет собой неполные антитела Ig. G, размеры которых в отличие от размеров полных агглютининов системы АВ 0 достаточно малы, чтобы они могли проникать через плацентарный барьер. • Реакции антиген антитело могут возникать и при несовместимости матери и плода по другим групповым признакам (в частности, АВ 0), однако такие реакции обычно бывают слабо выражены.
 Несовместимость матери и плода по системе АВ 0 предотвращает резус конфликт • эритроциты плода удаляются из организма матери уже имеющимися анти А или анти В агглютининами, и Rh фактор эритроцитов плода не успевает активировать иммунную систему матери.
Несовместимость матери и плода по системе АВ 0 предотвращает резус конфликт • эритроциты плода удаляются из организма матери уже имеющимися анти А или анти В агглютининами, и Rh фактор эритроцитов плода не успевает активировать иммунную систему матери.

 Вопрос 14 Определение резуспринадлежности
Вопрос 14 Определение резуспринадлежности
 Цоликлон Анти-D Супер • моноклональные антитела к D реагентам эритроцитов человека системы Резус, моноспецифичны. • Представляют собой разведенную солевым раствором культуральную жидкость, содержащую полные антитела анти D изотопа Ig. M, стабилизированную азидом натрия. • Применяется для типирования группы крови человека по системе Резус в реакции прямой агглютинации на плоскости, в пробирке и в микроплате. • Агглютинация эритроцитов в присутствии реагента анти D Супер (положительная реакция) свидетельствует о наличии в исследуемой крови D антигенов. • Без ограничений используется для типирования резус принадлежности крови реципиентов и доноров, дающих положительную реакцию с Цоликлоном анти D Супер. • Резус отрицательные доноры могут быть перепроверены Цоликлоном анти D.
Цоликлон Анти-D Супер • моноклональные антитела к D реагентам эритроцитов человека системы Резус, моноспецифичны. • Представляют собой разведенную солевым раствором культуральную жидкость, содержащую полные антитела анти D изотопа Ig. M, стабилизированную азидом натрия. • Применяется для типирования группы крови человека по системе Резус в реакции прямой агглютинации на плоскости, в пробирке и в микроплате. • Агглютинация эритроцитов в присутствии реагента анти D Супер (положительная реакция) свидетельствует о наличии в исследуемой крови D антигенов. • Без ограничений используется для типирования резус принадлежности крови реципиентов и доноров, дающих положительную реакцию с Цоликлоном анти D Супер. • Резус отрицательные доноры могут быть перепроверены Цоликлоном анти D.
 Цоликлон Анти-D • • • моноклональные антитела к D реагентам эритроцитов человека системы Резус, моноспецифичны. Выявляет в том числе слабый D антиген. Представляют собой разведенную солевым раствором культуральную жидкость, содержащую полные антитела анти D изотопа Ig. M, стабилизированную азидом натрия. Применяется для определения резус принадлежности крови человека в непрямом антиглобулиновом тесте, в реакции конглютинации с желатином или в реакции агглютинации с эритроцитами, обработанными протеолитическими ферментами. Агглютинация эритроцитов в присутствии реагента анти D (положительная реакция) свидетельствует о наличии в исследуемой крови D антигенов, в том числе слабого D u антигена. Используется для типирования резус принадлежности крови реципиентов и доноров без ограничений.
Цоликлон Анти-D • • • моноклональные антитела к D реагентам эритроцитов человека системы Резус, моноспецифичны. Выявляет в том числе слабый D антиген. Представляют собой разведенную солевым раствором культуральную жидкость, содержащую полные антитела анти D изотопа Ig. M, стабилизированную азидом натрия. Применяется для определения резус принадлежности крови человека в непрямом антиглобулиновом тесте, в реакции конглютинации с желатином или в реакции агглютинации с эритроцитами, обработанными протеолитическими ферментами. Агглютинация эритроцитов в присутствии реагента анти D (положительная реакция) свидетельствует о наличии в исследуемой крови D антигенов, в том числе слабого D u антигена. Используется для типирования резус принадлежности крови реципиентов и доноров без ограничений.
 Цоликлон Редких специфичностей • Редкие специфичности: анти-С, анти-Е, анти-с, анти-е, анти-Kell и др.
Цоликлон Редких специфичностей • Редкие специфичности: анти-С, анти-Е, анти-с, анти-е, анти-Kell и др.
 • Для определения резус фактора в настоящее время используют стандартную сыворотку, содержащую определенный титр агглютининов или цоликлон анти-D.
• Для определения резус фактора в настоящее время используют стандартную сыворотку, содержащую определенный титр агглютининов или цоликлон анти-D.
 • Действующим началом цоликлона анти D являются антитела, принадлежащие к классу иммуноглобулинов М. • Они вызывают прямую агглютинацию эритроцитов, содержащих резус фактор.
• Действующим началом цоликлона анти D являются антитела, принадлежащие к классу иммуноглобулинов М. • Они вызывают прямую агглютинацию эритроцитов, содержащих резус фактор.
 • На пластину со смачиваемой поверхностью наносится большая капля (около 0, 1 мл) реагента, рядом помещается маленькая капля (0, 01— 0, 05 мл) исследуемой крови. Затем кровь смешивается с реагентом. • Реакция агглютинации начинается через 10 — 15 с, четко выраженная агглютинация наступает через 30 — 60 с.
• На пластину со смачиваемой поверхностью наносится большая капля (около 0, 1 мл) реагента, рядом помещается маленькая капля (0, 01— 0, 05 мл) исследуемой крови. Затем кровь смешивается с реагентом. • Реакция агглютинации начинается через 10 — 15 с, четко выраженная агглютинация наступает через 30 — 60 с.
 • Использование подогретой до температуры 37 ‑ 40 °С пластинки сокращает время наступления агглютинации. Результаты реакции учитывайте через 3 мин. • Пластинку после смешивания реагента с кровью покачивают не сразу, а через 20 — 30 с, что позволяет за это время развиться более полной крупнолепестковой агглютинации.
• Использование подогретой до температуры 37 ‑ 40 °С пластинки сокращает время наступления агглютинации. Результаты реакции учитывайте через 3 мин. • Пластинку после смешивания реагента с кровью покачивают не сразу, а через 20 — 30 с, что позволяет за это время развиться более полной крупнолепестковой агглютинации.
 Вопрос 15 Определение индивидуальной совместимости крови
Вопрос 15 Определение индивидуальной совместимости крови
 Прямая перекрестная биологическая проба • Эритроциты донора смешивают на стекле со свежей сывороткой реципиента при 37 °С. • Цель пробы сводится к определению в сыворотке реципиента антител к эритроцитам донора. • Переливание крови возможно лишь при безусловно отрицательном результате прямой пробы, т. е. при отсутствии агглютинации или гемолиза.
Прямая перекрестная биологическая проба • Эритроциты донора смешивают на стекле со свежей сывороткой реципиента при 37 °С. • Цель пробы сводится к определению в сыворотке реципиента антител к эритроцитам донора. • Переливание крови возможно лишь при безусловно отрицательном результате прямой пробы, т. е. при отсутствии агглютинации или гемолиза.
 Обратная перекрестная биологическая проба • Эритроциты реципиента смешивают на стекле со свежей сывороткой донора при 37 °С. • Цель пробы сводится к определению в сыворотке донора антител к эритроцитам реципиента.
Обратная перекрестная биологическая проба • Эритроциты реципиента смешивают на стекле со свежей сывороткой донора при 37 °С. • Цель пробы сводится к определению в сыворотке донора антител к эритроцитам реципиента.
 Вопрос 16 Инновации в определении групп крови
Вопрос 16 Инновации в определении групп крови
 Диагностическая система для типирования эритроцитов и определения антиэритроцитарных антител Dia. Med ID Mycro Typing System (Швейцария) • используется для проведения всего спектра изосерологических исследований, основанных на реакции гемагглютинации, включая АВО/Rh типирование эритроцитов; типирование антигенов эритроцитов других систем; • спектр реакций на совместимость крови донора и реципиента;
Диагностическая система для типирования эритроцитов и определения антиэритроцитарных антител Dia. Med ID Mycro Typing System (Швейцария) • используется для проведения всего спектра изосерологических исследований, основанных на реакции гемагглютинации, включая АВО/Rh типирование эритроцитов; типирование антигенов эритроцитов других систем; • спектр реакций на совместимость крови донора и реципиента;









 Вопрос 17 Физиологические основы донорства
Вопрос 17 Физиологические основы донорства

 Что способствовало возникновению донорства? 1. Открытие У. Гарвеем кровообращения (1628) 2. Открытие К. Ландштейнером групповых факторов крови (1900). 3. Предложение русского врача В. Юревича в 1914 году (!!!) (и одновременно его бельгийскими и американскими коллегами) консервировать кровь раствором цитрата натрия.
Что способствовало возникновению донорства? 1. Открытие У. Гарвеем кровообращения (1628) 2. Открытие К. Ландштейнером групповых факторов крови (1900). 3. Предложение русского врача В. Юревича в 1914 году (!!!) (и одновременно его бельгийскими и американскими коллегами) консервировать кровь раствором цитрата натрия.
 • В 1926 г. в Москве был создан первый в мире Институт переливания крови. • Во многих городах появились станции переливания крови. • Широкое развитие получило безвозмездное донорство, научные основы которого разработаны Л. Г. Богомоловой.
• В 1926 г. в Москве был создан первый в мире Институт переливания крови. • Во многих городах появились станции переливания крови. • Широкое развитие получило безвозмездное донорство, научные основы которого разработаны Л. Г. Богомоловой.

 Из донорской крови обычно производят три основных компонента: • суспензию эритроцитов • свежезамороженную плазму • концентрат тромбоцитов
Из донорской крови обычно производят три основных компонента: • суспензию эритроцитов • свежезамороженную плазму • концентрат тромбоцитов
 для спасения жизней пациентов, нуждающихся в переливании крови, доноры необходимы постоянно. • Так кровь донора остается качественной лишь короткое время (срок хранения красной крови примерно 50 дней)
для спасения жизней пациентов, нуждающихся в переливании крови, доноры необходимы постоянно. • Так кровь донора остается качественной лишь короткое время (срок хранения красной крови примерно 50 дней)
 Виды донорства Донор может сдать • плазму крови, • цельную кровь • кровь на тромбоциты Можно быть донором костного мозга, точнее, гемопоэтических (т. е. кроветворных) клеток. • В кровь донора вводят препарат, стимулирующий выработку кроветворных клеток, а затем его кровь прогоняют через сепаратор, отделяющий гемопоэтические клетки. • Эта процедура похожа на сдачу крови.
Виды донорства Донор может сдать • плазму крови, • цельную кровь • кровь на тромбоциты Можно быть донором костного мозга, точнее, гемопоэтических (т. е. кроветворных) клеток. • В кровь донора вводят препарат, стимулирующий выработку кроветворных клеток, а затем его кровь прогоняют через сепаратор, отделяющий гемопоэтические клетки. • Эта процедура похожа на сдачу крови.

 Как часто можно сдавать кровь без ущерба для здоровья? • Кровь восстанавливается в течение месяца. • Сдавать кровь рекомендуется три пять раз в год с интервалами в три месяца. • После пяти регулярных кровосдач лучше сделать перерыв на три четыре месяца.
Как часто можно сдавать кровь без ущерба для здоровья? • Кровь восстанавливается в течение месяца. • Сдавать кровь рекомендуется три пять раз в год с интервалами в три месяца. • После пяти регулярных кровосдач лучше сделать перерыв на три четыре месяца.
 Вопросы часто задаваемые
Вопросы часто задаваемые
 • Меняется ли группа крови у человека в течение жизни? • Нет, но…
• Меняется ли группа крови у человека в течение жизни? • Нет, но…
 Но… • Международная группа исследователей под руководством датчанина Хенрика Клаузена (2007) разработала способ удалять с поверхности эритроцитов антигены А и В. • Для этого используются высокоэффективные ферменты, выделенные из бактерий Elizabethkingia meningosepticum и Bacteroides fragilis. • Проблему антител в плазме крови это не решает, но очищенная от антигенов эритроцитарная масса будет пригодной для переливания реципиентам с любой группой
Но… • Международная группа исследователей под руководством датчанина Хенрика Клаузена (2007) разработала способ удалять с поверхности эритроцитов антигены А и В. • Для этого используются высокоэффективные ферменты, выделенные из бактерий Elizabethkingia meningosepticum и Bacteroides fragilis. • Проблему антител в плазме крови это не решает, но очищенная от антигенов эритроцитарная масса будет пригодной для переливания реципиентам с любой группой
 • Если группа крови не меняется тогда её можно зафиксировать навсегда в паспорте, водительском удостоверении, на одежде …?
• Если группа крови не меняется тогда её можно зафиксировать навсегда в паспорте, водительском удостоверении, на одежде …?
 Кровью паспорт не испортишь • Мне исполнилось 45 лет, нужно менять паспорт. В старом у меня стоял штамп о группе крови. Для меня это очень важно, так как резус фактор отрицательный. Можно ли перенести эти данные в новый документ. И не признают ли его из за этого недействительным. Вон скольким людям испортили документы украинские таможенники, поставив отметку о пересечении границы. Нелли Алексеевна • Действительно, внесение не предусмотренных записей делает паспорт недействительным. • Но отметки о группе крови и ее резус – принадлежности к таковым не относятся. • По вашей просьбе медицинские учреждения могут поставить в документ установленный штамп.
Кровью паспорт не испортишь • Мне исполнилось 45 лет, нужно менять паспорт. В старом у меня стоял штамп о группе крови. Для меня это очень важно, так как резус фактор отрицательный. Можно ли перенести эти данные в новый документ. И не признают ли его из за этого недействительным. Вон скольким людям испортили документы украинские таможенники, поставив отметку о пересечении границы. Нелли Алексеевна • Действительно, внесение не предусмотренных записей делает паспорт недействительным. • Но отметки о группе крови и ее резус – принадлежности к таковым не относятся. • По вашей просьбе медицинские учреждения могут поставить в документ установленный штамп.
 Группа крови на рукаве 120. 00 руб
Группа крови на рукаве 120. 00 руб



